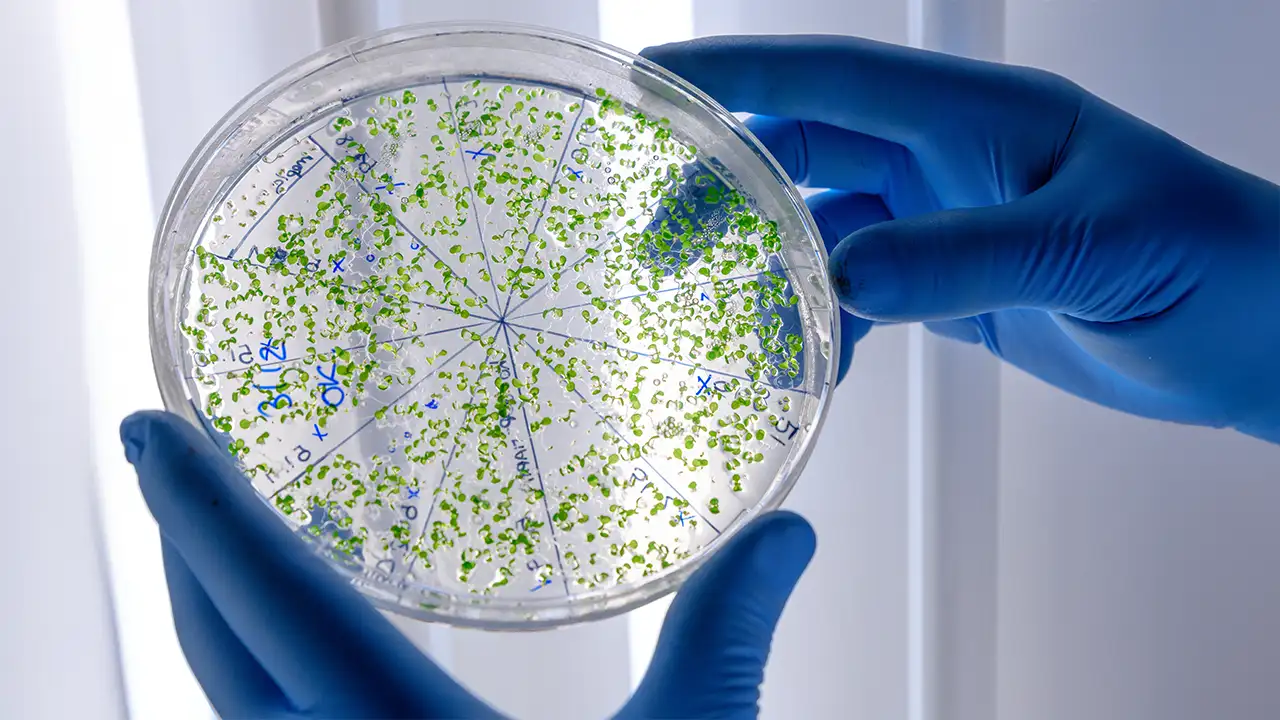
enzimas fazendo reciclagem biológica de plástico PET

Durante décadas, o plástico foi o vilão imortal dos oceanos e aterros sanitários. Aprendemos que uma garrafa PET leva mais de 400 anos para desaparecer, exigindo séculos para que a natureza faça o trabalho. Mas, em 2025, a natureza — com uma ajudinha da engenharia genética e da inteligência artificial — mudou essa regra. A era da reciclagem mecânica, cara e ineficiente, está dando lugar à revolução da reciclagem biológica.
Cientistas e empresas de biotecnologia confirmaram este ano a eficácia em escala industrial de “superbactérias” e enzimas modificadas capazes de digerir plástico. O que antes era uma curiosidade de laboratório agora é uma ferramenta real para limpar o planeta. O objetivo final é transformar os resíduos plásticos de trilhões de dólares em um recurso valioso e inesgotável.
A Natureza Contra-Ataca: Como a Enzima Funciona
O conceito parece ficção científica: microrganismos que usam o plástico como alimento. O processo, conhecido como reciclagem biológica ou enzimática, baseia-se em enzimas naturais, como a PETase, identificada pela primeira vez em um centro de reciclagem no Japão.
Essas enzimas agem como “tesouras moleculares”, conforme detalhado em diversos estudos científicos. Elas cortam as cadeias longas de polímeros do PET (o plástico das garrafas, por exemplo) em seus blocos básicos e originais, chamados monômeros.
Esta quebra molecular é o que realmente revoluciona a economia circular:
- Reciclagem Tradicional (Downcycling): Derrete o plástico e diminui sua qualidade e resistência. O material reciclado só pode ser usado em produtos de valor inferior (como carpetes ou enchimento), encerrando o ciclo em poucas vidas úteis.
- Reciclagem Biológica (Upcycling): A digestão enzimática devolve o material ao seu estado químico virgem, puro e de alta qualidade. Isso significa que uma garrafa velha pode virar uma camiseta nova, ou outra garrafa, infinitamente, sem precisar de uma gota de petróleo novo. O ciclo se torna verdadeiramente fechado e sustentável.
Velocidade Impressionante: Acelerado pela Inteligência Artificial
A grande novidade de 2024/2025 não é a descoberta da enzima, mas a velocidade e a eficiência que a ciência alcançou. As primeiras cepas naturais eram lentas, levando semanas para degradar apenas um pedaço de filme plástico. Isso tornava o processo inviável em termos industriais e econômicos.
No entanto, com a ajuda de modelagem computacional e inteligência artificial, pesquisadores conseguiram modificar geneticamente essas enzimas e criar “coquetéis” enzimáticos que operam em temperaturas mais elevadas e de forma muito mais rápida.
As novas variantes enzimáticas aprimoradas conseguem despolimerizar 90% de uma tonelada de plástico PET em menos de 10 horas. É uma eficiência que torna o processo não apenas viável, mas economicamente competitivo com a produção de plástico virgem para grandes centros urbanos e indústrias, fechando o ciclo da economia circular de verdade.
O Impacto no Mundo Real e a Oportunidade Econômica
Já estamos vendo essa tecnologia sair do papel. Plantas piloto de empresas como a francesa Carbios estão operando na Europa, e projetos de pesquisa avançados no Brasil (como os da Uniso e FAPESP) estão utilizando essas enzimas para tratar resíduos que antes eram considerados “lixo perdido”.
Conforme detalha a CNN Brasil sobre os avanços de pesquisadores brasileiros, a ciência está não só resolvendo um problema, mas criando uma nova cadeia de valor.
A reciclagem biológica não só limpa o ambiente, mas também gera valor de duas formas:
- Matéria-Prima Virgem: Cria monômeros de alta pureza para a fabricação de novos plásticos de qualidade premium.
- Bioprodutos: O subproduto da digestão pode ser convertido em bioplásticos biodegradáveis ou compostos químicos valiosos para a indústria.
Transformamos um problema ambiental de trilhões de dólares em uma oportunidade econômica sustentável, incentivando a coleta e o processamento do lixo plástico.
Os Próximos Passos para um Futuro Mais Limpo
Apesar do otimismo, ainda há desafios. A tecnologia precisa garantir que essas enzimas funcionem fora de ambientes de bioreatores controlados, lidando com diferentes tipos de plásticos misturados e resíduos mais complexos. Os cientistas já estão trabalhando para desenvolver enzimas que consigam degradar outros tipos de polímeros, como o polietileno (PE) e o polipropileno (PP), comuns em sacolas e embalagens rígidas.
Mas o caminho para o futuro passwordless do plástico (sem a “senha” da durabilidade) está traçado. Não estamos mais apenas empilhando lixo para as futuras gerações. Pela primeira vez, temos a tecnologia para desfazer o dano de forma rápida e eficiente, devolvendo à natureza apenas o que ela consegue absorver e mantendo na economia o que é valioso, graças à reciclagem biológica.
O Bom do Mundo é um portal fundado por um empreendedor com 32 anos de experiência em Comunicação e Marketing, apaixonado por tecnologia. Nossa missão editorial é combater a narrativa negativa, entregando apenas notícias positivas que geram impacto real e acessível para o homem, os animais e o planeta. Com foco em Inovação e Expertise, nossa equipe garante a curadoria de conteúdo de alta qualidade.